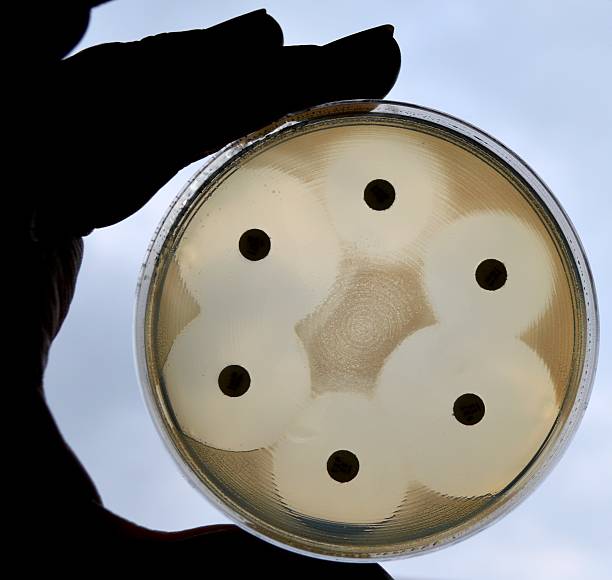

生きていなくとも良いバクテリア
2024/12/21
生きていなくとも良いバクテリア
これを医療用に上手く応用しものが抗生剤です。
また仲間や子孫のために体の内外に有益な成分を分泌したり溜めたりします。
酒、味噌、醤油、味の素など私たちの食生活にはそれらの働きで作り出されたものがたくさんあります。
その成分によっては他の菌と共存できたり、場合によっては相乗効果によって単独で生存するよりも活性が高まる事もあります。
人間の健康維持に大きな関わりを持っているとされる腸内細菌の存在が近年クローズアップされています。その分野では
・プロバイオテクス
・プレバイオテクス
という一文字違いのよく似た二つの用語が使われます。

プロバイオテクスとはお腹の腸内細菌のバランスを整え、腸内の異常状態を改善し、健康に良い影響を与えてくれる生きた微生物のことです。
つまり乳酸菌やビフィズス菌などの生きている菌群を指します。
プレバイオテクスはプロバイオティクスの働きを助ける物質のことです。
オリゴ糖や食物繊維などが代表的なものとして知られています。
こちらは生きていなくとも良いのです。
乳酸菌飲料に含まれている乳酸菌群の大部分は、強酸である胃液によって殺されてしまいますが、乳酸菌飲料を摂ると体調が良くなることを私たちは経験的に知っています。
この場合、乳酸菌はプロバイオテクスとしてではなくプレバイオテクスとして効力を発揮しているようにも思われます。
飲料内の様々な成分や乳酸菌の体内成分などが作用して腸内細菌の活性が高まると考えられるからです。
100億個の乳酸菌を含んでいると謳う某社の青汁がCMで流されていますが、その100億個は死んでいる乳酸菌で、乳酸菌死菌と呼ばれるものです。
死菌メーカーの肩を持つわけではありませんが、死んでいる菌でも生きている菌と遜色のない効果をしまします。
ここでの乳酸菌に求められるのは乳酸菌の体内成分であって、生きた乳酸菌の活躍ではないのです。
私たちが水槽の環境維持のために用いる様々なバクテリア資材についても同様の概念が当てはまります。
硝化菌や脱窒菌、バチルス菌などは水槽内で彼等が働くことを前提として投入するわけですから、それらの菌群は投入時に生きていなければなりません。
バクテリアそのものは本来排他的なものです。
すでに水槽内で勢力を伸ばしている「先住の菌」たちに駆逐されずに定着するためには相応の「菌体数」が必要になります。
飲まず食わずでヘロヘロになった新参者の菌がほんの少し飛び込んだとしても彼等の運命はまさに風前の灯になってしまうと思いませんか?
そんな菌同士の戦いの様を想像してみると、市販のバクテリア資材の在り方には大きな不安や不信を感じてしまうのです。

一方プレバイオテクス的な意味合いで投入するバクテリアとしては、その代表格として「光合成細菌」の名前が真っ先に浮かんできます。
「PSB」などとも呼ばれることもある、あの赤い色をした液体です。
日本動物医薬品が出している「たね水」と言う商品は緑色をした光合成細菌です。
「たね水」は私たち素人が培養すると赤くなってしまいます。
光合成細菌は通常塩分のない水で培養することが多く、淡水の水槽に投入された場合は生きた菌の直接の働きを期待することができるので、この場合はプロバイオティクスと呼ばれてもおかしくはありません。
しかし淡水で培養した光合成細菌を海水水槽に投入してもかなりの効果があることは多くのユーザーが経験しています。
海水中に投入された淡水育ちの光合成細菌はおそらく短時間のうちに死んでしまうのではないかと想像します。
その場合には光合成細菌は海水中で生きて働いたのではなく、死んだ光合成細菌の体内成分によってもともと海水水槽内に生息していた既存の細菌の活性が高められたと考える必要があります。
まさにプレバイオテクスではないでしょうか。
光合成細菌が生きているに越したことはないのですが、培養するときに彼等が作り出す「自分たちの仲間や子孫繁栄に有効な物質」が培養液の中には大量に存在します。
あの赤くて臭い液体の中には、生きた光合成細菌と一緒にこれらの有用成分がたっぷりと含まれています。
これらの成分は光合成細菌にだけでなく、他の細菌にも有効成分として取り込まれ、その活性を高めることになるのです。
土の中には「放線菌」と呼ばれる菌がいます。
彼等は植物の病気を引き起こす病原菌をコントロールする拮抗作用を示します。
つまり耕作地に放線菌が増えると作物は病気になりにくくなるのです。
畑や田んぼに光合成細菌を散布すると地中の放線菌が増えることが知られています。
どうやら光合成細菌は放線菌の餌として取り込まれているようなのです。
光合成細菌の体内やその培養液中に含まれる様々な有用成分が、作物への肥料として取り込まれるばかりでなく、放線菌を増やすという効果も含めて作物の健康状態にまで関与する因果関係が想像されます。
結核の特効薬として知られるストレプトマイシンという抗生物質があります。
これはストレプトマイセス属の放線菌から作り出されたことからその名が付けられました。
人間の大腸内に棲む代表的な善玉菌であるビフィズス菌も放線菌に近い仲間です。
インドでは光合成細菌をワインで割って飲むという伝承医療があるそうです。
結果としてビフィズス菌が増えて腸内細菌がもたらす免疫機能が高まるという因果関係があるのかもしれません。
水槽の環境改善に光合成細菌を用いる意味は、菌自身が生きた状態で水槽内の様々な要因を改善するという可能性もさることながら、もともと水槽内に先住している水質維持に関与する様々な常在菌群を、人間で言うところの腸内細菌のように、耕作地で言えば放線菌のようにその数を増やしたり活性を高めたりすることで、結果として環境改善に寄与するのではないでしょうか。
この場合、光合成細菌が生きているか死んでいるかはさほど重要な条件ではなく、あくまでも菌体内や菌体外の有用物質の種類や量の方が意味を持っているのではなかろうかと考えています。
極論ですが、私は光合成細菌は高価なものをチビリチビリ使うより、多少氏素性の怪しいものでも大量に投入した方が効果があるのでは無いかと考えています。
なぜなら光合成細菌がプレバイオティクスとして機能するなら質よりも量の世界のような気がするからです。
その意味で、光合成細菌を自家培養できることはあなたが大きなアドバンテージを持つことになるのです。




